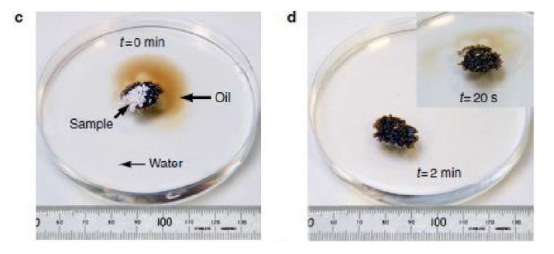
1607393903276613.png image.png

一文了解多孔氮化硼(BN):一种具有广泛应用前景的材料
【产品介绍】:
一文了解多孔氮化硼(BN):一种具有广泛应用前景的材料
自从氮化硼成为材料界的新星后,对其应用的拓展研究逐渐得到了人们的重视。在这个过程中,科学家发现,相对于普通块状的氮化硼来说,多孔氮化硼由于具有较高的比表面积,因此应用范围更广泛,在吸附剂、催化剂载体、储氢材料等领域上都具有很好的应用效果,成为了近年来的研究热点。
六方氮化硼的晶体结构
虽然氮化硼有三种晶体结构,①类石墨的六方氮化硼(h-BN);②密排六方氮化硼(w-BN);③类似于金刚石的立方氮化硼(c-BN),但其中应用广、同时也可以做成多孔材料的就是六方氮化硼。作为一种摩氏硬度为2的软性材料,h-BN能表现出较强的机械性能、热学性能及化学稳定性,因此具有很高的可塑性。

一、多孔氮化硼有哪些应用前景?
多孔陶瓷本身便具有相对密度低、比表面积大、重量轻等优点,具体可表现为较高的强度、刚度、冲击韧性,良好的阻波性能、光电性能、吸附性能等。而当“多孔”遇上h-BN时,强强联合下h-BN的应用得到了进一步的拓展,具体如下:
1.催化剂载体
由于多孔氮化硼具有高比表面积、化学惰性、耐高温等优良特点,因为研究者们开始利用这些优势将其制备为催化剂载体。如中国科学院杨晓龙等人利用MgO/h-BN复合载体负载的Ru基氨合成催化剂对氨合成反应进行催化,由于MgO/h-BN载体上存在较多的碱性位,所以表现出优秀的催化活性;G.Postole等人利用两种不同比表面积的氮化硼作为负载剂,钯作为催化剂对丙烯氧化反应进行催化。结果发现氮化硼中含有氧元素时负载的氧化钯催化剂比纯氮化硼的催化效果更好。

银纳米颗粒与氮化硼的混合结构,用于催化转化CO
2.吸附剂
高比表面积的氮化硼不仅可以用来做催化剂载体,做吸附剂也同样很给力。目前应用多的吸附剂是活性炭(500m2/g-1200m2/g),由于其来源广泛、比表面积大、吸附容量大,所以经常被用于水处理、空气过滤等方面。
影响材料吸附能力的关键在于它的比表面积大小,目前已有学者对高比表面积氮化硼展开吸附试验,如蔡等人研究了高比表面积氮化硼对水中氯苯的吸附规律,通过静态吸附法研究发现氮化硼对氯苯的吸附过程符合一级动力学模型和Freundlich等温吸附模型,氮化硼对于氯苯的吸附饱和量可达到672.8mg/g,去除率高达79%。相比于活性炭对氯苯的去除率只有61.73%,氮化硼表现出较好的吸附效果。
多孔氮化硼可用于吸附油污
3.储氢材料
由于氮化硼材料类似于石墨结构,所以氮化硼可以形成纳米管,并且通过实验研究发现氮化硼纳米管有许多性质要优于碳纳米管,如程等人通过研究采用巨正则蒙特卡罗方法,系统地研究了常温和中等压强下锂掺杂SWBNNTA的物理吸附储氢特性,揭示了在现有条件下Li-dopedSWBNNTA的储氢量能够达到和超过美国能源部提出的2015研究目标。Weng等人用三聚氰胺和硼酸作为前躯体制备了多孔氮化硼纳米带,比表面积高达1488m2/g,储氢性能十分卓越。
氮化硼纳米带得形貌和氢气吸附-脱附曲线

西安齐岳生物提供定制产品:
黄素单核甘酸(FMN)共价修饰氮化硼纳米管(FMN/BNNTs)
镍包六方氮化硼 (Ni/h-BN) 纯金属包覆型金属-陶瓷复合粉末
以上资料来自先齐岳生物小编zhn220.12.08




 德尔塔官方微信
德尔塔官方微信